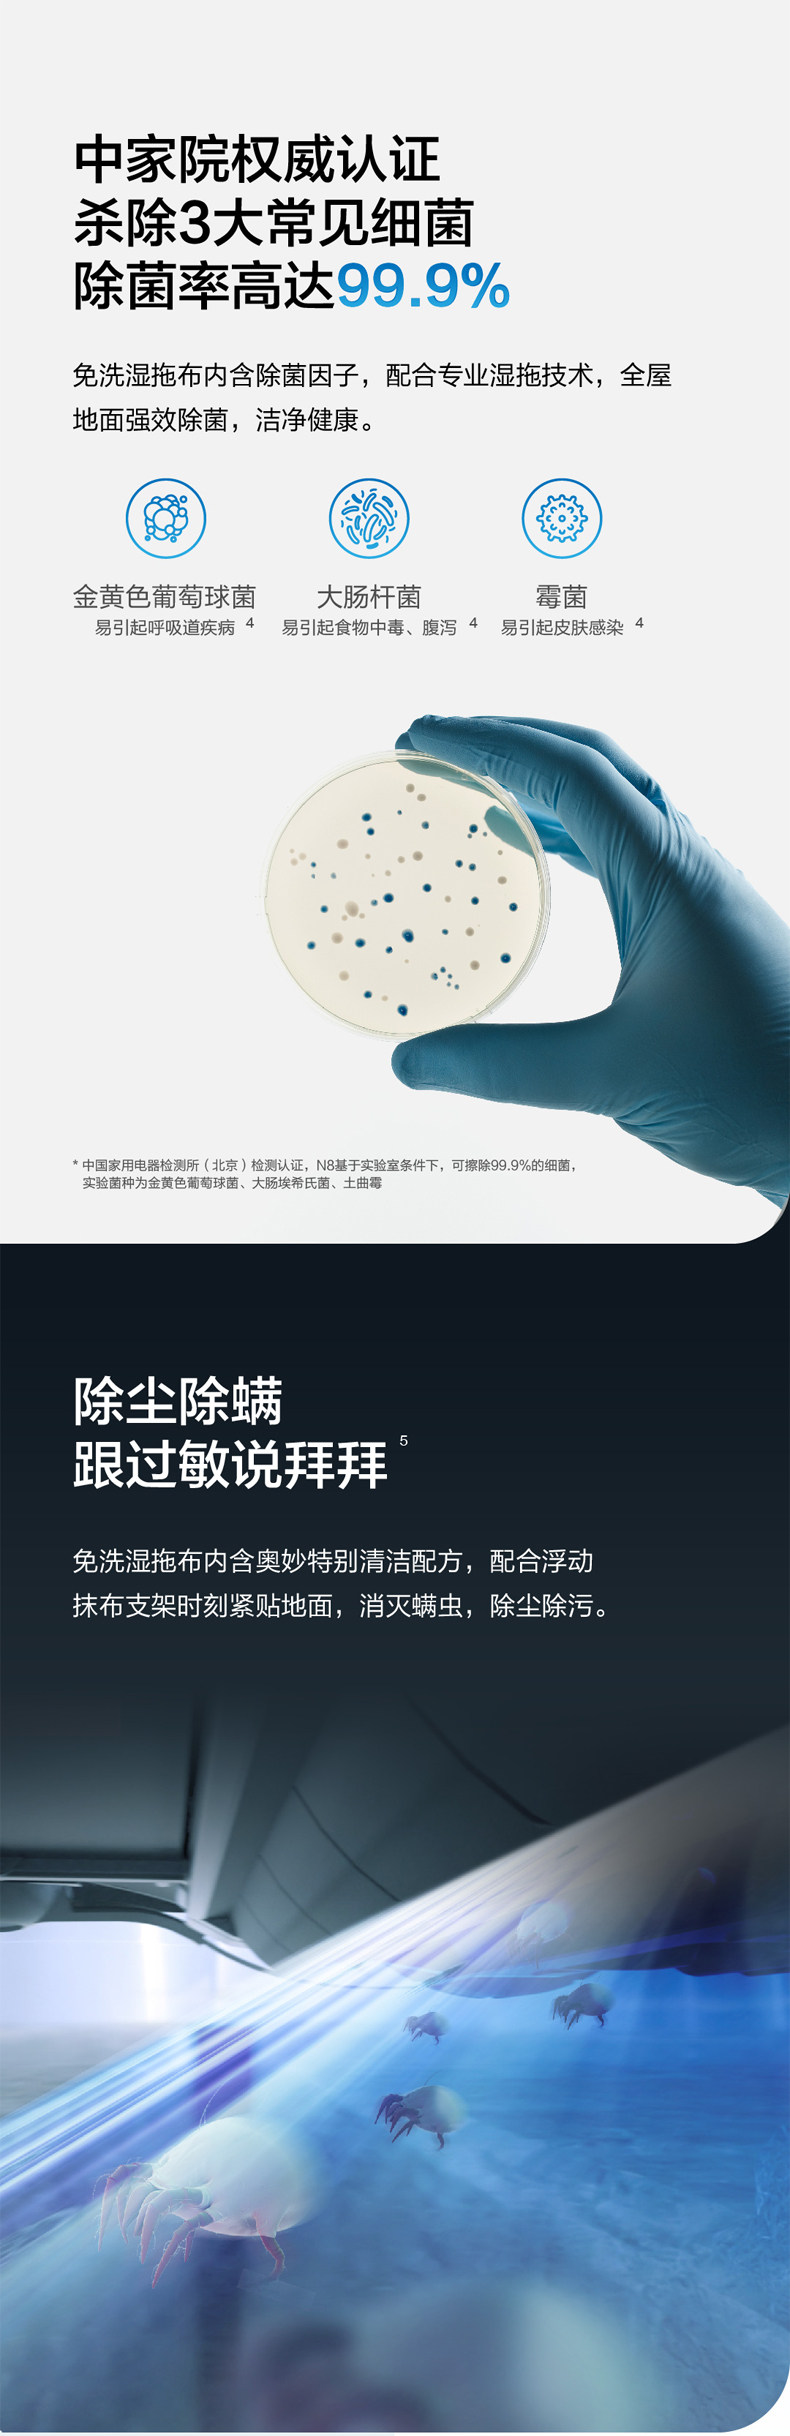

- Таобао
- Техника
- Бытовая техника
- Электрические щетки для уборки
- 628804602872
COBOS N8 Широкий робот по полу с сокровищами Smart Home Полный автомат.

Цена: 46 847руб. (¥2199)
Артикул: 628804602872
Вес товара: ~0.7 кг. Указан усредненный вес, который может отличаться от фактического. Не включен в цену, оплачивается при получении.
Описание товараPHA+PGltZyBzcmM9Imh0dHBzOi8vaW1nLmFsaWNkbi5jb20vaW1nZXh0cmEvaTMvMjg3ODA5MTM2Ny9PMUNOMDFTV3ZRQ1UxTHk4M25qRHRsdl8hITI4NzgwOTEzNjcuanBnIiBhbGlnbj0iYWJzbWlkZGxlIj48aW1nIHNyYz0iaHR0cHM6Ly9pbWcuYWxpY2RuLmNvbS9pbWdleHRyYS9pMS8yODc4MDkxMzY3L08xQ04wMVE0Y0FETDFMeTgzeXduUVNsXyEhMjg3ODA5MTM2Ny5qcGciIGFsaWduPSJhYnNtaWRkbGUiPjxpbWcgc3JjPSJodHRwczovL2ltZy5hbGljZG4uY29tL2ltZ2V4dHJhL2kzLzI4NzgwOTEzNjcvTzFDTjAxdjVLZ25FMUx5ODN0RFVrUnlfISEyODc4MDkxMzY3LmpwZyIgYWxpZ249ImFic21pZGRsZSI+PGltZyBzcmM9Imh0dHBzOi8vaW1nLmFsaWNkbi5jb20vaW1nZXh0cmEvaTQvMjg3ODA5MTM2Ny9PMUNOMDFxRE5TSm0xTHk4NDd6Y0RrNV8hITI4NzgwOTEzNjcucG5nIiBhbGlnbj0iYWJzbWlkZGxlIj48aW1nIHNyYz0iaHR0cHM6Ly9pbWcuYWxpY2RuLmNvbS9pbWdleHRyYS9pMi8yODc4MDkxMzY3L08xQ04wMWVkblh4UTFMeTgzVEVWUnhGXyEhMjg3ODA5MTM2Ny5wbmciIGFsaWduPSJhYnNtaWRkbGUiPjxpbWcgc3JjPSJodHRwczovL2ltZy5hbGljZG4uY29tL2ltZ2V4dHJhL2kyLzI4NzgwOTEzNjcvTzFDTjAxOUdJeGR5MUx5ODQ0M2RYejhfISEyODc4MDkxMzY3LnBuZyIgYWxpZ249ImFic21pZGRsZSI+PGltZyBzcmM9Imh0dHBzOi8vaW1nLmFsaWNkbi5jb20vaW1nZXh0cmEvaTIvMjg3ODA5MTM2Ny9PMUNOMDF1RGVBNTQxTHk4NDQzZGM4eV8hITI4NzgwOTEzNjcuanBnIiBhbGlnbj0iYWJzbWlkZGxlIj48aW1nIHNyYz0iaHR0cHM6Ly9pbWcuYWxpY2RuLmNvbS9pbWdleHRyYS9pMi8yODc4MDkxMzY3L08xQ04wMVh5QVVYcjFMeTgzUDF4cnZNXyEhMjg3ODA5MTM2Ny5wbmciIGFsaWduPSJhYnNtaWRkbGUiPjxpbWcgc3JjPSJodHRwczovL2ltZy5hbGljZG4uY29tL2ltZ2V4dHJhL2kzLzI4NzgwOTEzNjcvTzFDTjAxUUw1blZJMUx5ODQySFVjVE5fISEyODc4MDkxMzY3LnBuZyIgYWxpZ249ImFic21pZGRsZSI+PGltZyBzcmM9Imh0dHBzOi8vaW1nLmFsaWNkbi5jb20vaW1nZXh0cmEvaTMvMjg3ODA5MTM2Ny9PMUNOMDFZQW1DRU0xTHk4NEFrSDBJcF8hITI4NzgwOTEzNjcucG5nIiBhbGlnbj0iYWJzbWlkZGxlIj48aW1nIHNyYz0iaHR0cHM6Ly9pbWcuYWxpY2RuLmNvbS9pbWdleHRyYS9pMy8yODc4MDkxMzY3L08xQ04wMVpvWXZzdzFMeTgzTThMcmR6XyEhMjg3ODA5MTM2Ny5wbmciIGFsaWduPSJhYnNtaWRkbGUiPjxpbWcgc3JjPSJodHRwczovL2ltZy5hbGljZG4uY29tL2ltZ2V4dHJhL2k0LzI4NzgwOTEzNjcvTzFDTjAxVHV0UENWMUx5ODNORlptUlRfISEyODc4MDkxMzY3LnBuZyIgYWxpZ249ImFic21pZGRsZSI+PGltZyBzcmM9Imh0dHBzOi8vaW1nLmFsaWNkbi5jb20vaW1nZXh0cmEvaTMvMjg3ODA5MTM2Ny9PMUNOMDF6aENvNVoxTHk4M2FqdEhHZV8hITI4NzgwOTEzNjcuanBnIiBhbGlnbj0iYWJzbWlkZGxlIj48aW1nIHNyYz0iaHR0cHM6Ly9pbWcuYWxpY2RuLmNvbS9pbWdleHRyYS9pMi8yODc4MDkxMzY3L08xQ04wMU5Na3Q1SDFMeTgzNmJJODRqXyEhMjg3ODA5MTM2Ny5qcGciIGFsaWduPSJhYnNtaWRkbGUiPjxpbWcgc3JjPSJodHRwczovL2ltZy5hbGljZG4uY29tL2ltZ2V4dHJhL2kzLzI4NzgwOTEzNjcvTzFDTjAxRFV5SFEwMUx5ODJ6M05tNjlfISEyODc4MDkxMzY3LmpwZyIgYWxpZ249ImFic21pZGRsZSI+PGltZyBzcmM9Imh0dHBzOi8vaW1nLmFsaWNkbi5jb20vaW1nZXh0cmEvaTQvMjg3ODA5MTM2Ny9PMUNOMDFvSDFSbXYxTHk4MzVRcDlkWV8hITI4NzgwOTEzNjcuanBnIiBhbGlnbj0iYWJzbWlkZGxlIj48aW1nIHNyYz0iaHR0cHM6Ly9pbWcuYWxpY2RuLmNvbS9pbWdleHRyYS9pMy8yODc4MDkxMzY3L08xQ04wMUpsUHFHZjFMeTgyeWJZdDVDXyEhMjg3ODA5MTM2Ny5qcGciIGFsaWduPSJhYnNtaWRkbGUiPjxpbWcgc3JjPSJodHRwczovL2ltZy5hbGljZG4uY29tL2ltZ2V4dHJhL2kyLzI4NzgwOTEzNjcvTzFDTjAxUTUzR1F2MUx5ODJzcllBYlhfISEyODc4MDkxMzY3LmpwZyIgYWxpZ249ImFic21pZGRsZSI+PGltZyBzcmM9Imh0dHBzOi8vaW1nLmFsaWNkbi5jb20vaW1nZXh0cmEvaTMvMjg3ODA5MTM2Ny9PMUNOMDF6Nmptek8xTHk4MnliWEQ2UF8hITI4NzgwOTEzNjcuanBnIiBhbGlnbj0iYWJzbWlkZGxlIj48aW1nIHNyYz0iaHR0cHM6Ly9pbWcuYWxpY2RuLmNvbS9pbWdleHRyYS9pMy8yODc4MDkxMzY3L08xQ04wMTZUM3plWjFMeTgzMWd2TVh1XyEhMjg3ODA5MTM2Ny5qcGciIGFsaWduPSJhYnNtaWRkbGUiPjxpbWcgc3JjPSJodHRwczovL2ltZy5hbGljZG4uY29tL2ltZ2V4dHJhL2kyLzI4NzgwOTEzNjcvTzFDTjAxSkNjRjhKMUx5ODM1UXFZeGdfISEyODc4MDkxMzY3LmpwZyIgYWxpZ249ImFic21pZGRsZSI+PGltZyBzcmM9Imh0dHBzOi8vaW1nLmFsaWNkbi5jb20vaW1nZXh0cmEvaTEvMjg3ODA5MTM2Ny9PMUNOMDFmWE0xTjkxTHk4MzBtWjlBTV8hITI4NzgwOTEzNjcuanBnIiBhbGlnbj0iYWJzbWlkZGxlIj48aW1nIHNyYz0iaHR0cHM6Ly9pbWcuYWxpY2RuLmNvbS9pbWdleHRyYS9pNC8yODc4MDkxMzY3L08xQ04wMWFHZVlGUjFMeTgzM2JTRXRUXyEhMjg3ODA5MTM2Ny5qcGciIGFsaWduPSJhYnNtaWRkbGUiPjxpbWcgc3JjPSJodHRwczovL2ltZy5hbGljZG4uY29tL2ltZ2V4dHJhL2kyLzI4NzgwOTEzNjcvTzFDTjAxdXhacGdvMUx5ODMxOXAzckxfISEyODc4MDkxMzY3LmpwZyIgYWxpZ249ImFic21pZGRsZSI+PGltZyBzcmM9Imh0dHBzOi8vaW1nLmFsaWNkbi5jb20vaW1nZXh0cmEvaTEvMjg3ODA5MTM2Ny9PMUNOMDFtUHFQQTkxTHk4MzRtdHB5bV8hITI4NzgwOTEzNjcuanBnIiBhbGlnbj0iYWJzbWlkZGxlIj48aW1nIHNyYz0iaHR0cHM6Ly9pbWcuYWxpY2RuLmNvbS9pbWdleHRyYS9pNC8yODc4MDkxMzY3L08xQ04wMTRJTTBzTzFMeTgzNVFva2dOXyEhMjg3ODA5MTM2Ny5qcGciIGFsaWduPSJhYnNtaWRkbGUiPjxpbWcgc3JjPSJodHRwczovL2ltZy5hbGljZG4uY29tL2ltZ2V4dHJhL2kxLzI4NzgwOTEzNjcvTzFDTjAxVEF1RFpKMUx5ODM0bXVFd0dfISEyODc4MDkxMzY3LmpwZyIgYWxpZ249ImFic21pZGRsZSI+PC9wPg==
Продавец:科沃斯奕瑾专卖店
Адрес:Шанхай
Рейтинг:

Всего отзывов:0
Положительных:0
Выберите вариацию / цвет
Добавить в корзину
- Информация о товаре
- Фотографии
| Цвет: | Белый |